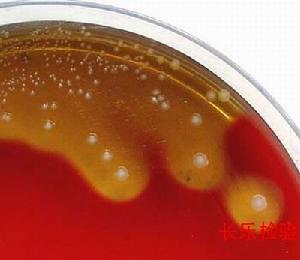
葡萄球菌腦膜炎

簡介
 葡萄球菌腦膜炎
葡萄球菌腦膜炎發病原因
葡萄球菌腦膜炎
葡萄球菌腦膜炎腦室-心房及腦室-腹腔引流術後,約10-30%發生細菌性腦膜炎,50%的病原為表皮葡萄球菌,金黃色葡萄球菌也占一定比例。
症狀
 葡萄球菌腦膜炎
葡萄球菌腦膜炎起病後發熱伴持久而劇烈的頭痛,頸項強直明顯。病初常出現蕁麻疹樣、猩紅熱樣皮疹或小膿皰,可有皮膚黏膜瘀點。膿皰性瘀點或紫癜,或有皮下膿腫存在,對診斷有幫助。
本病病程中,病人可出現硬膜下積液、積膿或腦積水,因顱底炎症粘連可致第Ⅱ、Ⅲ、Ⅵ、Ⅶ及Ⅷ對腦神經損害。並發腦膿腫者,偶可發生肢體癱瘓。
治療
 葡萄球菌腦膜炎
葡萄球菌腦膜炎金黃色葡萄球菌腦膜炎的病死率甚高,可達50%以上。治療宜選用苯唑西林,成人每日8-12g,兒童每日150-200mg/kg,分次靜滴,同時口服丙磺舒。若對青黴過敏或治療效果不好,可改用萬古黴素聯合磷黴素或利福平。萬古黴素每日2g,兒童每日50mg/kg,分次靜滴。利福平的成人劑量為600-9OOmg/天,兒童每日l5mg/kg,分二次口服,用藥期間定期隨訪肝、腎功能。
萬古黴素不易通過血腦屏障,治療期間最好配合慶大黴素鞘內注射,慶大黴素鞘內注射每次5000-10000u(5~10mg),兒童每次1000-2000u(l-2mg)。磷黴素的毒性小,對各種葡萄球菌均具抗菌活性,且可進入各組織和腦脊液中。但細菌易對磷黴素產生耐藥,治療時宜聯合用藥。成人劑量為16-20g/天,分2次靜脈滴注。葡萄球菌腦膜炎較易復發,故療程宜較長,體溫正常後繼續用藥2周,或腦脊液正常後繼續用藥1周,療程常在3周以上。治療期間應予適當支持治療,顱內壓明顯增高者給脫水劑。
